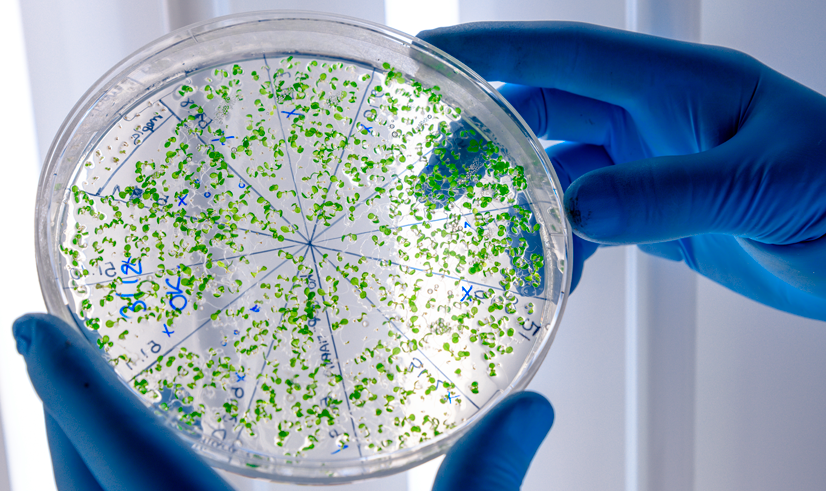

Vamos Transformar o Mundo! Objetivos de Desenvolvimento Sustentável - ONU Brasil
descrição
Evento virtual
Público-alvo: Alunos de graduação em Direito.
Programação completa:
Palestra com o Dr. Carlos Eduardo Annechino Pereira Miguel sobre os objetivos de desenvolvimento sustentável – ONU Brasil.
Horário: 18h30.
A transmissão será via Microsoft Teams.
Para acessar a live, clique aqui.
Programação
cursos que
podem interessar
Tem dúvidas ou precisa de ajuda?
Faça
aqui sua
inscrição
Tem dúvidas ou precisa de ajuda?
documentos necessários
Vestibular Tradicional e Agendado
Diploma / Certificado de conclusão do Ensino Médio. Se concluído fora do Brasil, declaração de Equivalência fornecida pelo Conselho Estadual de Educação (original e cópia);
Escolar do Ensino Médio (original e cópia);
Página do Diário Oficial, com a publicação do nome (para os concluintes do Ensino Médio a partir de 1985), para Escolas do RJ e Bahia (cópia autenticada e cópia comum);
Documento de Identidade (original e cópia);
CPF (original e cópia);
Certidão de Nascimento ou Casamento (original e cópia);
Uma foto 3x4;
Comprovante de Residência (original e cópia);
Contrato assinado (assinatura e rubrica em todas as páginas).
ENEM
Faça sua matrícula on-line rapidamente. Apresente cópia do boletim do ENEM, que é enviado pelos Correios, ou imprima no site do ENEM.
Diploma / Certificado de conclusão do Ensino Médio. Se concluído fora do Brasil, declaração de Equivalência fornecida pelo Conselho Estadual de Educação (original e cópia);
Histórico Escolar do Ensino Médio (original e cópia);
Página do Diário Oficial, com a publicação do nome (para os concluintes do Ensino Médio a partir de 1985), para Escolas do RJ e Bahia (cópia autenticada e cópia comum);
Documento de Identidade (original e cópia);
CPF (original e cópia);
Certidão de Nascimento ou Casamento (original e cópia);
Uma foto 3x4;
Comprovante de Residência (original e cópia);
Contrato assinado (assinatura e rubrica em todas as páginas).
Pós-Graduação
Faça sua inscrição no formulário no site. Após o pagamento da primeira cota do semestre letivo, apresente os seguintes documentos:
Diploma de curso superior registrado (original e cópia);
Histórico escolar da Instituição de Ensino Superior;
Documento de Identidade (original e cópia);
CPF (original e cópia);
Certidão de Nascimento ou Casamento (original e cópia);
Uma foto 3x4;
Comprovante de Residência (original e cópia);
Contrato assinado (assinatura e rubrica em todas as páginas);
Título de eleitor (original e cópia);
Documento Militar (para homens)
Extensão
Faça sua inscrição no formulário no site. Após o pagamento da primeira cota, apresente os seguintes documentos na Central de Admissão:
Comprovante de pagamento da primeira cota;
Declaração de escolaridade (original e cópia);
Certidão de nascimento ou casamento (original e cópia);
RG e CPF (original e cópia);
Comprovante de residência (original e cópia);
Duas fotos 3x4.
X